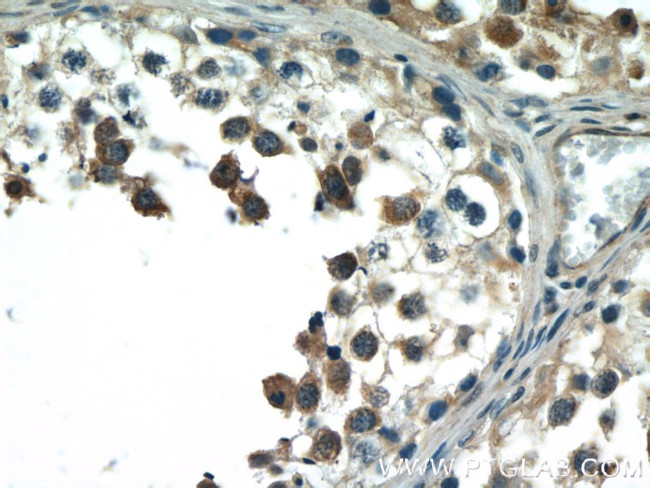
BCMO1 Antibody in Immunohistochemistry (Paraffin) (IHC (P))

Search
Proteintech
BCMO1 Polyclonal Antibody
{{$productOrderCtrl.translations['antibody.pdp.commerceCard.promotion.promotions']}}
{{$productOrderCtrl.translations['antibody.pdp.commerceCard.promotion.viewpromo']}}
{{$productOrderCtrl.translations['antibody.pdp.commerceCard.promotion.promocode']}}: {{promo.promoCode}} {{promo.promoTitle}} {{promo.promoDescription}}. {{$productOrderCtrl.translations['antibody.pdp.commerceCard.promotion.learnmore']}}
产品信息
23308-1-AP
种属反应
宿主/亚型
分类
类型
抗原
偶联物
形式
浓度
规格
纯化类型
保存液
内含物
保存条件
运输条件
产品详细信息
Immunogen sequence: FKIPATVPE GKKQGKSPWK HTEVFCSIPS RSLLSPSYYH SFGVTENYVI FLEQPFRLDI LKMATAYIRS MSWASCLAFH REEKTYIHII DQRTRQPVQT KFYTDAMVVF HHVNAYEEDG CIVFDVIAYE DNSLYQLFYL ANLNQDFKEN SRLTSVPTLR RFAVPLHVDK NAEVGTNLIK VASTTATALK EEDGQVYCQP EFLYEGLELP RVNYAHNGKQ YRYVFATGVQ WSPIPTKIIK YDILTKSSLK WREDDCWPAE PLFVPAPGAK DEDDGVILSA IVSTDPQKLP FLLILDAKSF TELARASVDV DMHMDLHGLF ITDMDWDTKK QAASEEQRDR ASDCHGAPLT (199-547 aa encoded by BC126210)
靶标信息
Vitamin A metabolism is important for vital processes such as vision, embryonic development, cell differentiation, and membrane and skin protection. The protein encoded by this gene is a key enzyme in beta-carotene metabolism to vitamin A. It catalyzes the oxidative cleavage of beta, beta-carotene into two retinal molecules.
仅用于科研。不用于诊断过程。未经明确授权不得转售。
篇参考文献 (0)
生物信息学
蛋白别名: Beta,beta-carotene 15,15'-dioxygenase; beta,beta-carotene 15,15'-monooxygenase; beta-carotene 15, 15'-dioxygenase 1; beta-carotene 15,15' dioxygenase; beta-carotene 15,15'-monooxygenase; beta-carotene 15,15'-monooxygenase 1; beta-carotene cleavage enzyme; Beta-carotene dioxygenase 1; Beta-carotene oxygenase 1; carotenoid-15,15'-oxygenase; dioxygenase; unnamed protein product
基因别名: BCDO; BCDO1; BCMO; BCMO1; BCO; BCO1; beta-CD; betaCMOOX; CMO1; Cmoi
UniProt ID: (Human) Q9HAY6, (Mouse) Q9JJS6
Entrez Gene ID: (Human) 53630, (Mouse) 63857